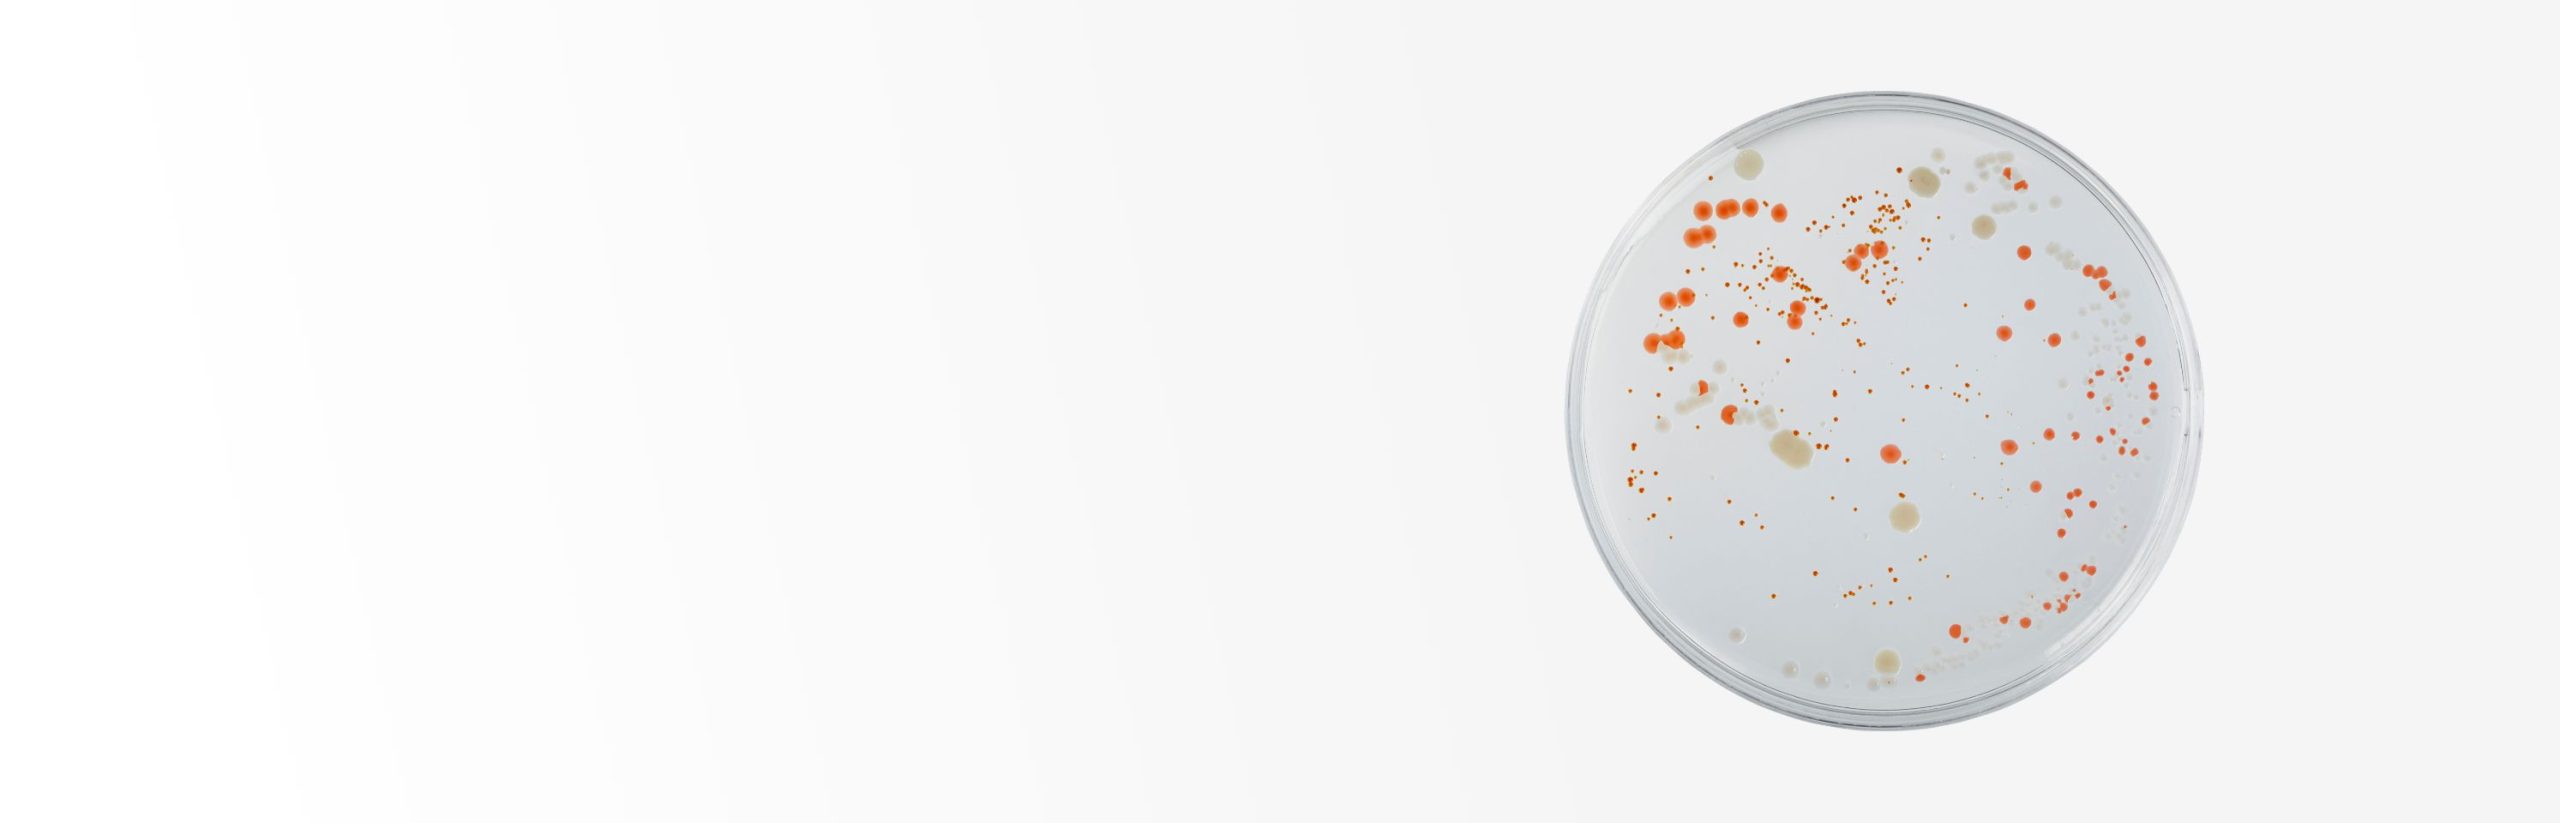
Indicator Organisms

Indicator Organisms
Safeguard your product quality and prevent costly recalls with Microbac’s ISO 17025 accredited indicator organism testing, offering tailored solutions to detect sanitation issues and mitigate risks across your supply chain
Indicator Organisms
A manufacturer’s food quality can be just as critical to successful sales as food safety testing. Indicator organism testing in your product, ingredients, and the environment can be critical in identifying not only sanitation issues, but also raise awareness to potential pathogen cross contamination before it happens. Paying attention to trends and spikes in indicator testing can prevent a client from a costly recall, loss of product, and extended shelf life. Microbac’s ISO 17025 accredited laboratories offer a variety of organisms and methods to meet any client’s complex needs. Our wide network of laboratories offers support solutions no matter where you’re located. Includes analysis for:
- Aerobic Plate Count
- Yeast and Mold
- Enterobacteriaceae
- Coliform
- Generic E. coli
- Staphylococcus aureus
- Lactic Acid Bacteria
- Clostridium Species
- Bacillus cereus
- Anaerobic Plate Count
Explore Our Food Catalog
For more information about lab offerings, methods, and locations for indicator organisms testing or other testing capabilities please visit our food catalog

Contact Us
Have questions or need expert testing solutions? Reach out to Microbac today, and let our team provide you with reliable and accurate testing services tailored to your needs. We’re here to support your business with trusted expertise.